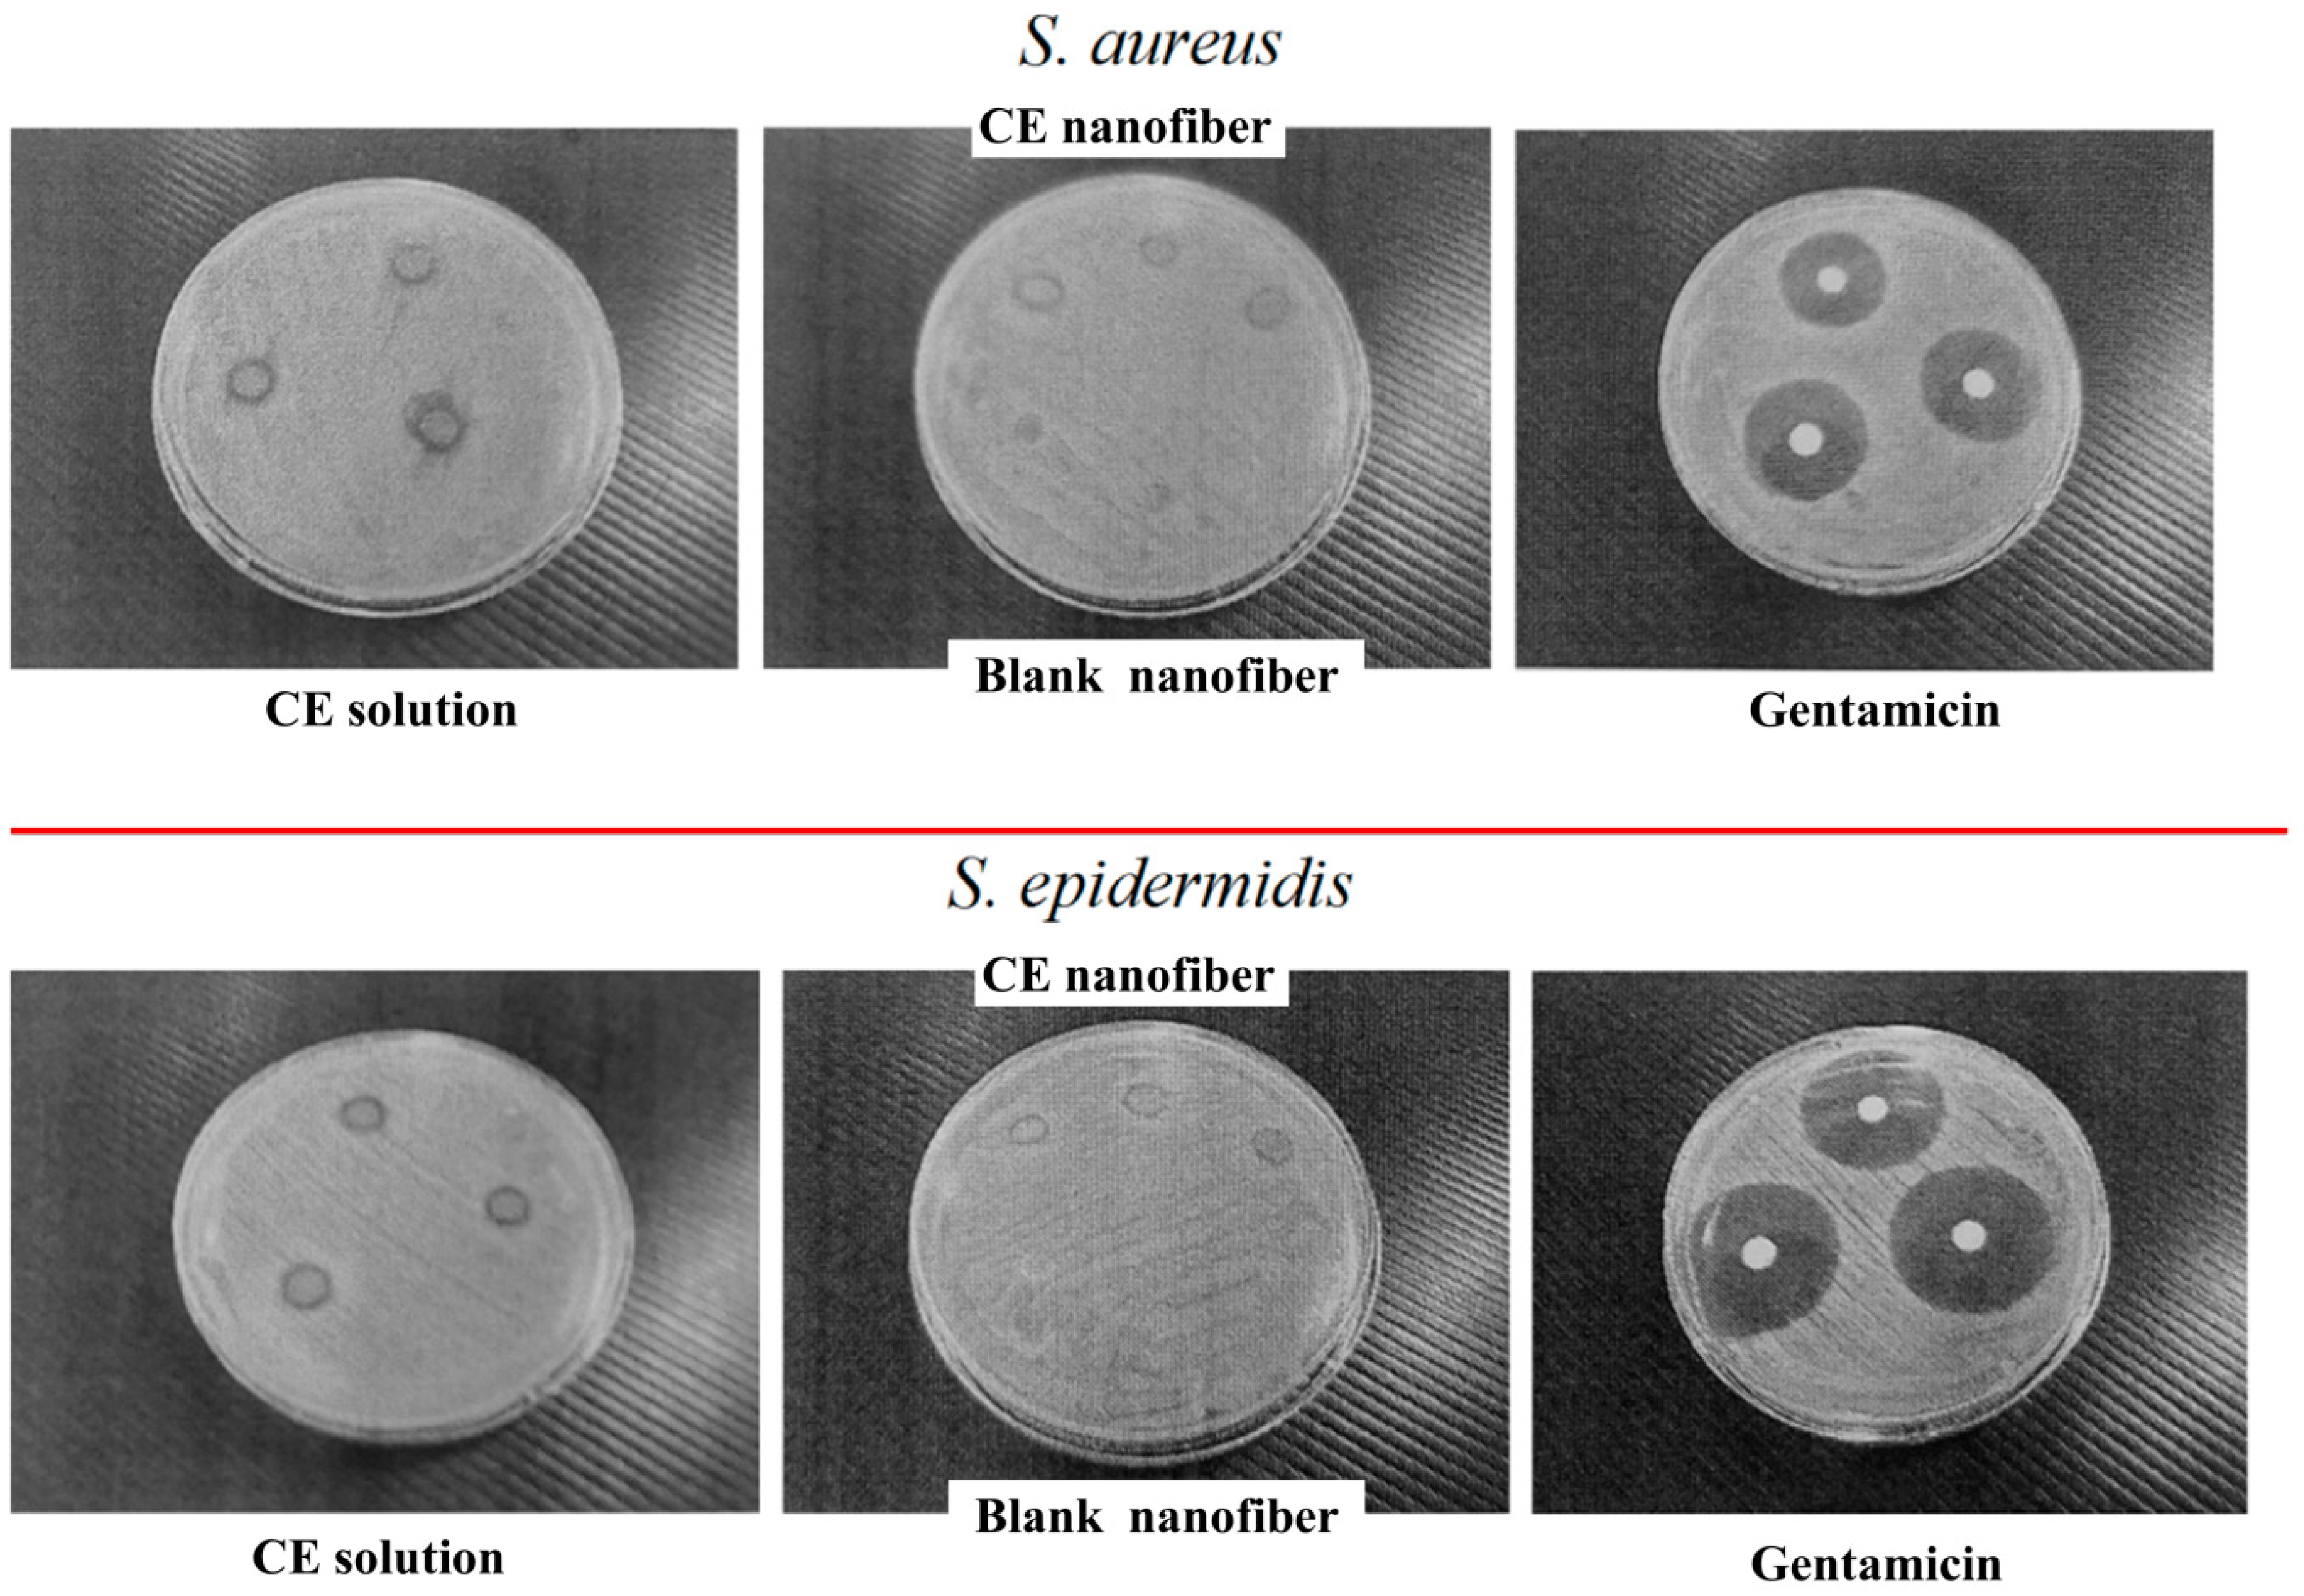
Fibers 07 00076 g006 550

Enhanced Stability and Bioactivity of Curcuma comosa Roxb. Extract in Electrospun Gelatin Nanofibers
Abstract
:1. Introduction
2. Experiments
2.1. Reagents and Apparatus
2.2. Preparation of Crude Ethanol Extract of Curcuma comosa Roxb. Rhizome Powder
2.3. Identification of Bioactive Compounds of the Crude Ethanol Extract of Curcuma comosa Roxb. Rhizome Powder
2.4. Electrospinning and Characterization of Gelatin Nanofibrous Mat
2.5. Studies of Characteristics of Electrospun Gelatin Nanofibers Loaded with the Crude Ethanol Extract of Curcuma comosa Roxb. Rhizome
2.6. Stability of Electrospun Gelatin Nanofibrous Mat Loaded with Crude Ethanol Extract of Curcuma comosa Roxb. Rhizome Powder
2.7. Statistical Analysis
3. Results and Discussion
3.1. Extraction and Characterisation of Diarylheptanoid Derivatives in Crude Ethanol Extract of Curcuma comosa Roxb. Rhizome Powder
3.2. Effect of Gelatin Concentrations on the Morphology of Electrospun Gelatin Nanofibers
3.3. Effect of Various Concentrations of Crude Ethanol Extract of Curcuma comosa Roxb. Rhizome Powderloaded on the Morphology of Electrospun Gelatin Nanofibers
3.4. Effect of Percent Loading on Anti-Oxidant Activity of Electrospun Gelatin Nanofibrous Mat Loaded with Crude Ethanol Extract of Curcuma comosa Roxb. Rhizome Powder
3.5. Effect of Percent Loading on Anti-Tyrosinase Activity of Electrospun Gelatin Nanofibrous Mat Loaded with Crude Ethanol Extract of Curcuma comosa Roxb. Rhizome Powder
3.6. Effect of Percent Loading on Antibacterial Activity of Electrospun Gelatin Nanofibrous Mat Loaded with Crude Ethanol Extract of Curcuma comosa Roxb. Rhizome Powder
3.7. Stability of Crude Extract-Loaded Gelatin Nanofibrous Mat
4. Conclusions
Supplementary Materials
Author Contributions
Funding
Acknowledgments
Conflicts of Interest
References
- Saensouk, S.; Saensouk, P.; Pasorn Chantaranothai, P. Diversity and uses of zingiberaceae in nam nao national park, chaiyaphum and phetchabun provinces, Thailand, with a new record for Thailand. Agric. Nat. Resour. 2016, 50, 445–453. [Google Scholar] [CrossRef]
- Su, J.; Sripanidkulchai, K.; Suksamrarn, A.; Hu, Y.; Piyachuturawat, P.; Sripanidkulchai, B. Pharmacokinetics and organ distribution of diarylheptanoid phytoestrogens from Curcuma comosa in rats. J. Nat. Med. 2012, 66, 468–475. [Google Scholar] [CrossRef] [PubMed]
- Winuthayanon, W.; Suksen, K.; Boonchird, C.; Chuncharunee, A.; Ponglikitmongkol, M.; Suksamrarn, A.; Piyachaturawat, P. Estrogenic Activity of Diarylheptanoids from Curcuma comosa Roxb. Requires Metabolic Activation. J. Agric. Food Chem. 2009, 57, 840–845. [Google Scholar] [CrossRef] [PubMed]
- Suksamrarn, A.; Eiamong, S.; Piyachaturawat, P.; Byrne, L.T. A Phloracetophenone Glucoside with Choleretic Activity from Curcuma comosa. Phytochemistry 1997, 45, 103–105. [Google Scholar] [CrossRef]
- Jurgens, T.M.; Frazier, E.G.; Schaeffer, J.M.; Jones, T.E.; Zink, D.L.; Borris, R.P.; Nanakorn, W.; Beck, H.T.; Balick, M.J. Novel nematocidal agents from Curcuma comosa. J. Nat. Prod. 1994, 57, 230–235. [Google Scholar] [CrossRef] [PubMed]
- Matsumoto, T.; Nakamura, S.; Fujimoto, K.; Ohta, T.; Ogawa, K.; Yoshikawa, M.; Onishi, E.; Fukaya, M.; Matsuda, H. Structure of diarylheptanoids with antiallergic activity from the rhizomes of Curcuma comosa. J. Nat. Med. 2015, 69, 142–147. [Google Scholar] [CrossRef] [PubMed]
- Wang, J.; Windbergs, M. Functional electrospun fibers for the treatment of human skin wounds. Eur. J. Pharm. Biopharm. 2017, 119, 283–299. [Google Scholar] [CrossRef] [PubMed]
- Li, T.; Zhang, D.; Oo, T.N.; San, M.M.; Mon, A.M.; Hein, P.P.; Wang, Y.; Lu, C.; Yang, X. Investigation on the Antibacterial and Anti-T3SS Activity of Traditional Myanmar Medicinal Plants. Evid. Based Complement. Altern. Med. 2018, 2018, 2812908. [Google Scholar] [CrossRef] [PubMed]
- Suksamrarn, A.; Ponglikitmongkol, M.; Wongkrajang, K.; Chindaduang, A.; Kittidanairak, S.; Jankam, A.; Yingyongnarongkul, A.B.E.; Kittipanumat, N.; Chokchaisiri, R.; Khetkam, P.; et al. Diarylheptanoids, new phytoestrogens from the rhizomes of Curcuma comosa: Isolation, chemical modification and estrogenic activity evaluation. Bioorganic Med. Chem. 2008, 16, 6891–6902. [Google Scholar] [CrossRef]
- Yingngam, B.; Brantner, A.; Jinarat, D.; Kaewamatawong, R.; Rungseevijitprapa, W.; Suksamrarn, A.; Piyachaturawat, P.; Chokchaisiri, R. Determination of the marker diarylheptanoid phytoestrogens in Curcuma comosa rhizomes and selected herbal medicinal products by HPLC-DAD. Chem. Pharm. Bull. 2018, 66, 65–70. [Google Scholar] [CrossRef]
- Intapad, S.; Saengsirisuwan, V.; Prasannarong, M.; Chuncharunee, A.; Suvitayawat, W.; Chokchaisiri, R.; Suksamrarn, A.; Piyachaturawat, P. Long-term effect of phytoestrogens from Curcuma comosa Roxb on vascular relaxation in ovariectomized rats. J. Agric. Food Chem. 2012, 60, 758–764. [Google Scholar] [CrossRef]
- Sodsai, A.; Piyachaturawat, P.; Sophasan, S.; Suksamrarn, A.; Vongsakul, M. Suppression by Curcuma comosa Roxb. of proinflammatory cytokine secretion in phorbol-12-myristate-13-acetate stimulated human mononuclear cells. Int. Immunopharmacol. 2007, 7, 524–531. [Google Scholar] [CrossRef] [PubMed]
- Wiseman, H. The therapeutic potential of phytoestrogens. Expert Opin. Investig. Drugs 2000, 9, 1829–1840. [Google Scholar] [CrossRef] [PubMed]
- Boonmee, A.; Srisomsap, C.; Chokchaichamnankit, D.; Karnchanatat, A.; Sangvanich, P. A proteomic analysis of Curcuma comosa Roxb. Rhizomes. Proteome Sci. 2011, 9, 43. [Google Scholar] [CrossRef] [PubMed]
- Xu, F.; Nakamura, S.; Qu, Y.; Matsuda, H.; Pongpiriyadacha, Y.; Wu, L.; Yoshikawa, M. Structures of New Sesquiterpenes from Curcuma comosa. Chem. Pharm. Bull. 2008, 56, 1710–1716. [Google Scholar] [CrossRef]
- Su, J.; Sripanidkulchai, K.; Hu, Y.; Chaiittianan, R.; Sripanidkulchai, B. Increased in situ intestinal absorption of phytoestrogenic diarylheptanoids from Curcuma comosa in nanoemulsions. Off. J. Am. Assoc. Pharm. Sci. 2013, 14, 1055–1062. [Google Scholar] [CrossRef] [PubMed]
- Ahn, B.K.; Lee, S.G.; Kim, S.R.; Lee, D.H.; Oh, M.H.; Lee, M.W.; Choi, Y.W. Inclusion compound formulation of hirsutenone with beta-cyclodextrin. J. Pharm. Investig. 2013, 43, 453–459. [Google Scholar] [CrossRef]
- Wani, T.A.; Shah, A.G.; Wani, S.M.; Wani, I.A.; Masoodi, F.A.; Nissar, N.; Shagoo, M.A. Suitability of different food grade materials for the encapsulation of some functional foods well reported for their advantages and susceptibility. Crit. Rev. Food Sci. Nutr. 2016, 56, 2431–2454. [Google Scholar] [CrossRef]
- Radhakrishnan, S.; Lakshminarayanan, R.; Madhaiyan, K.; Barathi, V.A.; Lim, K.H.C.; Ramakrishna, S. Electrosprayed nanoparticles and electrospun nanofibers based on natural materials: Applications in tissue regeneration, drug delivery and pharmaceuticals. Chem. Soc. Rev. 2015, 44, 790–814. [Google Scholar]
- STorres-Giner, R.; Pérez-Masiá, R.; Lagaron, J.M. A review on electrospun polymer nanostructures as advanced bioactive platforms. Polym. Eng. Sci. 2016, 56, 500–527. [Google Scholar] [CrossRef]
- Bhattarai, R.S.; Bachu, R.D.; Boddu, S.H.S.; Bhaduri, S. Biomedical Applications of Electrospun Nanofibers: Drug and Nanoparticle Delivery. Pharmaceutics 2019, 11, 5. [Google Scholar] [CrossRef] [PubMed]
- Papa, A.; Guarino, V.; Cirillo, V.; Oliviero, O.; Ambrosio, L. Optimization of Bicomponent Electrospun Fibers for Therapeutic Use: Post-Treatments to Improve Chemical and Biological Stability. J. Funct. Biomater. 2017, 8, 47. [Google Scholar] [CrossRef] [PubMed]
- Yang, F.; Miao, Y.; Wang, Y.; Zhang, L.M.; Lin, X. Electrospun Zein/Gelatin Scaffold-Enhanced Cell Attachment and Growth of Human Periodontal Ligament Stem Cells. Materials 2017, 10, 1168. [Google Scholar] [CrossRef] [PubMed]
- Nootem, J.; Chalorak, P.; Meemon, K.; Mingvanish, W.; Pratumyot, K.; Ruckthong, L.; Srisuwannaket, C.; Niamnont, N. Electrospun cellulose acetate doped with astaxanthin derivatives from Haematococcus pluvialis for in vivo anti-aging activity. RSC Adv. 2018, 8, 37151–37158. [Google Scholar] [CrossRef]
- Zupacnic, S.; Baumgartner, S.; Lavric, Z.; Petelin, M.; Kristl, J. Local delivery of resveratrol using polycaprolactone nanofibers for treatment of periodontal disease. J. Drug. Deliv. Sci. Technol. 2015, 30, 408–416. [Google Scholar]
- El-Refaie, K.; Bowlin, G.L.; Mansfield, K.; Layman, J.; Simpson, D.G.; Sanders, E.H.; Wnek, G.E. Release of tetracycline hydrochloride from electrospun poly (ethylene-co-vinylacetate), poly (lactic acid), and a blend. J. Control. Release 2002, 81, 57–64. [Google Scholar]
- Chao, S.; Li, Y.; Zhao, R.; Zhang, L.; Li, Y.; Wang, C.; Li, X. Synthesis and characterization of tigecycline-loaded sericin/poly (vinyl alcohol) composite fibers via electrospinning as antibacterial wound dressings. J. Drug. Deliv Sci. Technol. 2018, 44, 440–447. [Google Scholar] [CrossRef]
- Zhu, L.F.; Chen, X.; Ahmad, Z.; Li, J.S.; Chang, M.W. Engineering of Ganoderma lucidum polysaccharide loaded polyvinyl alcohol nanofibers for biopharmaceutical delivery. J. Drug. Deliv Sci. Technol. 2019, 50, 208–216. [Google Scholar] [CrossRef]
- Ghorani, B.; Tucker, N. Fundamentals of electrospinning as a novel delivery vehicle for bioactive compounds in food nanotechnology. Food Hydrocoll. 2015, 51, 227–240. [Google Scholar] [CrossRef]
- Figueroa-Lopez, K.J.; Castro-Mayorga, J.L.; Andrade-Mahecha, M.M.; Cabedo, L.; Lagaron, J.M. Antibacterial and barrier properties of gelatin coated by electrospun polycaprolactone ultrathin fibers containing black pepper oleoresin of interest in active food biopackaging applications. Nanomaterials 2018, 8, 199. [Google Scholar] [CrossRef]
- Mogosanu, G.D.; Grumezescu, A.M. Natural and synthetic polymers for wounds and burns dressing. Int. J. Pharm. 2014, 463, 127–136. [Google Scholar] [CrossRef] [PubMed]
- Maytal, F.; Zilberman, M. Drug delivery from gelatin-based systems. Expert Opin. Drug Deliv. 2015, 12, 1547–1563. [Google Scholar]
- Nagarajan, S.; Soussan, L.; Bechelany, M.; Teyssier, C.; Cavailles, V.; Pochat-Bohatier, C.; Miele, P.; Kalkura, N.; Janot, J.M.; Balme, S. Novel biocompatible electrospun gelatin fiber mats with antibiotic drug delivery properties. J. Mater. Chem. B 2016, 4, 1134–1141. [Google Scholar] [CrossRef]
- Li, H.; Wang, M.; Williams, G.R.; Wu, J.; Sun, X.; Lv, Y.; Zhu, L.M. Electrospun gelatin nanofibers loaded with vitamins A and E as antibacterial wound dressing materials. RSC Adv. 2016, 6, 50267–50277. [Google Scholar] [CrossRef]
- Sutjarit, N.; Sueajai, J.; Boonmuen, N.; Sornkaew, N.; Suksamrarn, A.; Tuchinda, P.; Zhu, W.; Weerachayaphorn, J.; Piyachaturawat, P. Curcuma comosa reduces visceral adipose tissue and improves dyslipidemia in ovariectomized rats. J. Ethnopharmacol. 2018, 215, 167–175. [Google Scholar] [CrossRef]
- Prashanth, N.; Bhavani, N.L. Phytochemical analysis of two high yielding Curcuma longa varieties from Andhra Pradesh. Int. J. Life Sci. Biotechnol. Pharm. Res. 2013, 2, 103–108. [Google Scholar]
- Devi, K.P.; Suganthy, N.; Kesika, P.; Pandian, S.K. Bioprotective properties of seaweeds: In vitro evaluation of antioxidant activity and antimicrobial activity against food borne bacteria in relation to polyphenolic content. BMC Complement. Altern. Med. 2008, 8, 1–11. [Google Scholar] [CrossRef]
- Masamoto, Y.; Ando, H.; Murata, Y.; Shimoishi, Y.; Tada, M.; Takahata, K. Mushroom tyrosinase inhibitory activity of esculetin isolated from seeds of Euphorbia lathyris L. Biosci. Biotechnol. Biochem. 2003, 67, 631–634. [Google Scholar] [CrossRef]

| Sample | S. aureus | S. epidermidis | ||
|---|---|---|---|---|
| Inhibition Zone a (mm) | MIC (µg/mL) | Inhibition Zone a (mm) | MIC (µg/mL) | |
| CE solution | 9.80 ± 0.17 | 1000 | 9.93 ± 0.06 | 500 |
| Blank nanofiber | NA * | - | NA * | - |
| CE nanofiber | 7.77 ± 0.21 | - | 7.73 ± 0.12 | - |
| Gentamicin | 24.30 ± 0.00 | 0.25 | 30.50 ± 0.17 | 0.25 |
© 2019 by the authors. Licensee MDPI, Basel, Switzerland. This article is an open access article distributed under the terms and conditions of the Creative Commons Attribution (CC BY) license (http://creativecommons.org/licenses/by/4.0/).
Share and Cite
Chiu, C.-M.; Nootem, J.; Santiwat, T.; Srisuwannaket, C.; Pratumyot, K.; Lin, W.-C.; Mingvanish, W.; Niamnont, N. Enhanced Stability and Bioactivity of Curcuma comosa Roxb. Extract in Electrospun Gelatin Nanofibers. Fibers 2019, 7, 76. https://doi.org/10.3390/fib7090076
Chiu C-M, Nootem J, Santiwat T, Srisuwannaket C, Pratumyot K, Lin W-C, Mingvanish W, Niamnont N. Enhanced Stability and Bioactivity of Curcuma comosa Roxb. Extract in Electrospun Gelatin Nanofibers. Fibers. 2019; 7(9):76. https://doi.org/10.3390/fib7090076
Chicago/Turabian StyleChiu, Chi-Ming, Jukkrit Nootem, Thanapich Santiwat, Choladda Srisuwannaket, Kornkanya Pratumyot, Wei-Chao Lin, Withawat Mingvanish, and Nakorn Niamnont. 2019. "Enhanced Stability and Bioactivity of Curcuma comosa Roxb. Extract in Electrospun Gelatin Nanofibers" Fibers 7, no. 9: 76. https://doi.org/10.3390/fib7090076
APA StyleChiu, C.-M., Nootem, J., Santiwat, T., Srisuwannaket, C., Pratumyot, K., Lin, W.-C., Mingvanish, W., & Niamnont, N. (2019). Enhanced Stability and Bioactivity of Curcuma comosa Roxb. Extract in Electrospun Gelatin Nanofibers. Fibers, 7(9), 76. https://doi.org/10.3390/fib7090076

